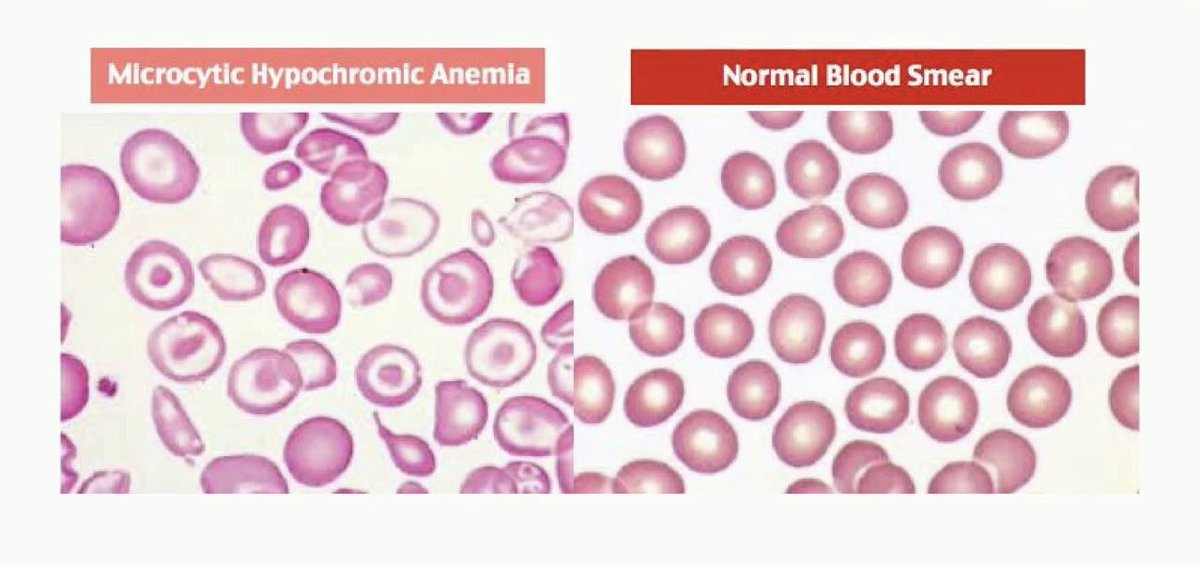

✨ في هذا الثريد راح أتكلم عن أنيميا نقص الحديد بداية من مسبباتها، ماهي أعراضها و مضاعفاتها، مين الشخص المعرض أكثر للاصابه فيها، كيف يتم تشخيصها أيضاً كيف يتم علاجها 👌🏻
يُعتبر من أكثر أنواع فقر الدم شيوعاً، يحدث بسبب نقص في الحديد ومخزونه بالجسم —> يؤدي الى نقص في عدد خلايا الدم الحمراء —> يؤدي الى نقص في عملية تزويد الجسم بالاوكسجين ولذلك من أهم علاماته هي التعب و ضيق في التنفس 👍🏻
💠 أسبابه:
▫️فقد دم - Blood Loss
▫️ غذاء يفتقد للحديد - Lack of iron rich diet
▫️عدم أمتصاص الحديد - Inability to absorb iron
عاده ما يتم أمتصاص الحديد في الامعاء الدقيقة، ولكن في بعض الامراض مثل الـ Celiac Disease تصيب القناة الهضمية وتمنع أمتصاص الحديد 👌🏻
▫️فقد دم - Blood Loss
▫️ غذاء يفتقد للحديد - Lack of iron rich diet
▫️عدم أمتصاص الحديد - Inability to absorb iron
عاده ما يتم أمتصاص الحديد في الامعاء الدقيقة، ولكن في بعض الامراض مثل الـ Celiac Disease تصيب القناة الهضمية وتمنع أمتصاص الحديد 👌🏻
▫️الحمل
بعض التغيرات الفسيولوجية مثل الحمل قد تؤدي الى نقص بالحديد لذلك أغلب الحوامل يُطلب منهم أكل مكملات الحديد خلال فترة الحمل 👍🏻
بعض التغيرات الفسيولوجية مثل الحمل قد تؤدي الى نقص بالحديد لذلك أغلب الحوامل يُطلب منهم أكل مكملات الحديد خلال فترة الحمل 👍🏻
💠 مضاعفاته:
▫️ مشاكل بالقلب - Heart Problems
مثل زيادة في الخفقان
▫️مشاكل في الحمل - Problems during pregnancy
حجم الطفل يكون أقل من الطبيعي أو يكون حديث الولادة Premature
▫️مشاكل في النمو - Growth Problems
قد يعاني الطفل من تأخر في النمو وأيضاً زيادة في القابلية للعدوى
▫️ مشاكل بالقلب - Heart Problems
مثل زيادة في الخفقان
▫️مشاكل في الحمل - Problems during pregnancy
حجم الطفل يكون أقل من الطبيعي أو يكون حديث الولادة Premature
▫️مشاكل في النمو - Growth Problems
قد يعاني الطفل من تأخر في النمو وأيضاً زيادة في القابلية للعدوى
💠 الاكثر عُرضة للاصابه:
▫️المرأة - Women
نقص في الدم خلال الـ Menstruation
▫️الاطفال والرضع - Infants and children
خصوصاً أطفال حديثي الولادة Premature أو يولدون ويكون لديهم نقص بالوزن
▫️المرأة - Women
نقص في الدم خلال الـ Menstruation
▫️الاطفال والرضع - Infants and children
خصوصاً أطفال حديثي الولادة Premature أو يولدون ويكون لديهم نقص بالوزن
💠 تشخيصه:
▫️ نقص في الـ MCV ⬇️
▫️ نقص في الـ MCH ⬇️
▫️ نقص في الـ MCHC ⬇️
▫️ نقص في الـ Serum Iron ⬇️
▫️ نقص في الـ Serum Ferritin ⬇️
▫️ نقص في الـ Transferrin Saturation ⬇️
▫️ زيادة في الـ RDW ⬆️
▫️ زيادة في الـ TIBC ⬆️
🌀 المعدل الطبيعي للحديد بالجسم من 3.5-5.0 g
▫️ نقص في الـ MCV ⬇️
▫️ نقص في الـ MCH ⬇️
▫️ نقص في الـ MCHC ⬇️
▫️ نقص في الـ Serum Iron ⬇️
▫️ نقص في الـ Serum Ferritin ⬇️
▫️ نقص في الـ Transferrin Saturation ⬇️
▫️ زيادة في الـ RDW ⬆️
▫️ زيادة في الـ TIBC ⬆️
🌀 المعدل الطبيعي للحديد بالجسم من 3.5-5.0 g
2️⃣ Non-Heme Iron - مصدرها نباتي مثل السبانخ والحبوب والمكسرات - معدل الامتصاص فيها أقل مقارنة بالـ Heme Iron، الزيادة منها لا بسبب مشاكل صحية
▫️ مُغذي بالوريد - IV Fluid
اذا كان هناك نقص حاد في الحديد ممكن يطلب الدكتور إعطاء المريض مُغذي بالوريد IV يحتوي على الحديد 👍🏻
اذا كان هناك نقص حاد في الحديد ممكن يطلب الدكتور إعطاء المريض مُغذي بالوريد IV يحتوي على الحديد 👍🏻
أنتهى الثريد 🙏
موفقين 👍🏻
موفقين 👍🏻
جاري تحميل الاقتراحات...